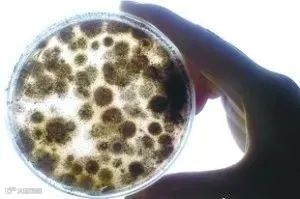

★首先解释一下什么是“底色”?
女士们在化妆之前,在脸上打上的那层粉底就是“底色”,在这层底色上画出来的妆,就显得比较好看。
★而在临床上很多病基本上都是发生在霉菌毒素基础之上的,尤其是那些疑难杂症(比如比较常见的腺肌胃炎等)都有霉菌毒素的影子,甚至有些病就是霉菌毒素引起的。所以霉菌毒素被认为是很多病的“底色病”。
★以前,霉菌及霉菌毒素被称为养殖业的“隐形杀手”,现在基本上已经得到公认是养殖业的“头号杀手”。级别在升级!
★霉菌毒素低浓度时可以引起免疫抑制、降低生产性能;严重一点可以损害动物内脏器官,表现出不同的临床症状;高浓度则可直接导致畜禽死亡。
★所以在养殖过程中防控好霉菌及霉菌毒素,是搞好养殖的基本条件,应该给予高度重视!

1、对霉菌毒素的特点不了解
2、对霉菌毒素的危害不了解
3、感觉用脱霉剂看不到明显变化
4、没吃过霉菌毒素的亏,心存侥幸

1、隐蔽性
1)我们通常对外表明显发霉的饲料或玉米,反应比较强烈;但是对外观看起来正常的饲料或玉米,就不那么在意了;事实上,外观正常的饲料或玉米,霉菌感染率一点都不低。

明显发霉 
玉米芯发霉

玉米粒轻微变化
2)玉米在地里生长的过程中就会受到各种霉菌病(类似于病虫害一样常见病)的感染,最常见的是赭曲霉、青霉菌、镰孢霉和麦角霉等,它们多是混合感染,严重的使玉米霉菌感染的症状比较明显,轻微的是隐藏在玉米粒当中,但外观正常。(如下图)

症状明显

中毒感染
雨季伏倒

玉米粒胚芽发霉

玉米在地里发芽

传统晾晒方法
3)仓储:
a、玉米储存的水分要求:不超过14%,有的要求在12.5%,但实际上都高达17%,甚至高达24%!

仓储水分要求在14%以内

玉米筒仓霉变现象图析
b、饲料刚生产出来,还热气腾腾在养殖场仓库储存过程中,容易“起热发捂、变酸变质”。

养殖场仓储
2)除了在田间、储存中、在养殖环节中(水线内、料槽内)也有很多细节被我们所忽略!(如下图)

水碗内饲料变酸

减压水箱污染

鸡吐水或拉到料槽内

料槽内饲料结块
2、普遍性
★通过以上分析可以看出,我们看不到的地方并不意味着没有霉菌感染,霉菌和霉菌毒素可以说是无处不在,尤其是在经常下雨比较湿润的南方地区,危害更大。如果玉米水分又在17%以上,更是容易发霉。
★很多人认为霉菌也仅在多雨潮湿的夏季会比较多些,事实证明,秋冬季节一点也不少,尤其是新玉米刚下来的时候,湿度一般都比较大,天气又不利于晾晒,更容易发霉,尤其是东北玉米被冻整个冬天。这也充分解释了为什么即使在寒冷的冬季,肉鸡腺胃炎依然很多的原因。腺胃炎最早发生在对比!现在的高发地依然在东北!
★还有些地方,能用上国家粮库更换下来的陈化粮,陈化粮最大的弊端就是存放时间长,捂了霉了,人不能吃了,就全给动物吃。
3、微量性(剧毒性)
剧毒
★ 1、我们通常认为,饲料稍微有点霉变应该没事,不会引起中毒,所以也就不在意。有些养殖场认为,加不加脱霉剂都无所谓,白白增加成本,所以就不怎么加,有的人甚至一点都不加。
★ 2、这是因为不知道霉菌毒素的安全水平是零!只要有极少的霉菌毒素的存在就会造成的伤害,而且这种危害会不断累积,最终总会表现出来。
★ 3、1mg的黄曲霉素就可以导致癌症发生,一次性摄入20mg黄曲霉素直接致成年人死亡,属剧毒物范围,毒性比是敌敌畏的100倍、氰化钾的10倍,砒霜的68倍。
★ 4、之所以家禽吃了发霉的饲料没有表现出症状,主要还是没有达到一定的量,还有就是肝脏的解毒功能,但是,如果经常吃,超出肝脏的极限之后呢!?(现在应该认识到保肝有多重要了吧)
★5、黄曲霉毒素是国际卫生组织认定的一级致癌物,其毒性和致癌性是所有霉菌毒素中最强的,也是肝脏的危害最大的
★而且在280度的高温下才能把黄曲霉毒素杀死。
4、累积性
★少量的霉菌毒素虽然没表现出什么症状,但霉菌毒素具有累积效应,即使含量很低也会影响畜禽生长,因为霉菌毒素没有安全量或最低标准。
★长期使用发霉的饲料,蓄积到一定程度,就会慢慢表现出各种症状,有的人直到症状明显,用别的药治疗无效时才意识到问题的严重性,才开始往霉菌上考虑,这个时候多半是有点晚了,因为霉菌毒素是直接伤害内脏器官,恢复起来太慢,有时候根本就恢复不过来。
★正所谓“冰冻三尺非一日之寒”,既然霉菌和霉菌毒素避无可避,就不应该等症状出现了在采取措施,一定要在平时就注重做“脱霉、解毒、保肝”等防控处理,把危害降到最低。
★ 5、所以,长期添加脱霉剂,可降低动物的发病率和死亡率,减少腹泻,提高饲料转化率,这是养殖增效的最有效最经济实惠的途径。
5、叠加性
★饲料中毒素检测不超标,那也未必安全:
★多种毒素往往同时存在,不同毒素之间存在协同效应,导致单一毒素不超标也可能致病。所以企业在制定现场标准时宜低于国家最高限量标准。
免责申明:本文所发资料信息来自互联网收集,主要用于供给大家学习、交流。我们尊重原创作者和单位,若本文侵犯了您的权益,请直接留言联系我们。



